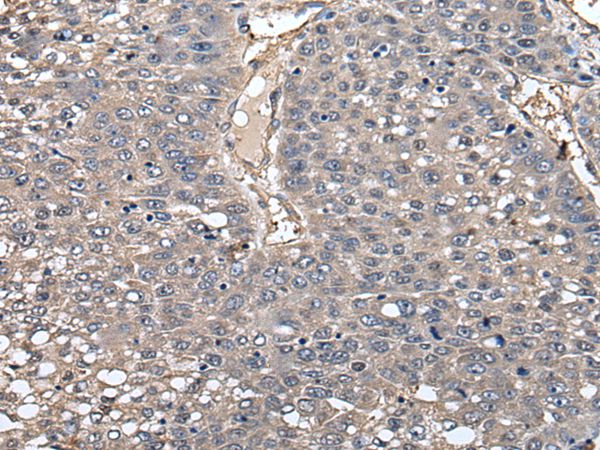
Anti-GCNT2 Antibody

Immunohistochemical staining of human Prostate shows strong granular cytoplasmic positivity in glandular cells.
Anti-GCNT2 Antibody
HPA026776
ApplicationsImmunoCytoChemistry, ImmunoHistoChemistry
Product group Antibodies
ReactivityHuman
TargetGCNT2
Overview
- SupplierAtlas Antibodies
- Product NameAnti-GCNT2 Antibody
- Delivery Days Customer4
- ApplicationsImmunoCytoChemistry, ImmunoHistoChemistry
- CertificationResearch Use Only
- ClonalityPolyclonal
- ConjugateUnconjugated
- Gene ID2651
- Target nameGCNT2
- Target descriptionglucosaminyl (N-acetyl) transferase 2 (I blood group)
- Target synonymsCCAT, CTRCT13, GCNT2C, GCNT5, IGNT, II, NACGT1, NAGCT1, ULG3, bA360O19.2, bA421M1.1, N-acetyllactosaminide beta-1,6-N-acetylglucosaminyl-transferase, I beta-1,6-N-acetylglucosaminyltransferase, Ii blood group, beta-1,6-N-acetylglucosaminyltransferase 2, glucosaminyl (N-acetyl) transferase 2, I-branching enzyme (I blood group)
- HostRabbit
- IsotypeIgG
- Protein IDQ8N0V5
- Protein NameN-acetyllactosaminide beta-1,6-N-acetylglucosaminyl-transferase
- Scientific DescriptionRecombinant Protein Epitope Signature Tag (PrEST) antigen sequence
- ReactivityHuman
- Storage Instruction-20°C,2°C to 8°C
- UNSPSC41116161